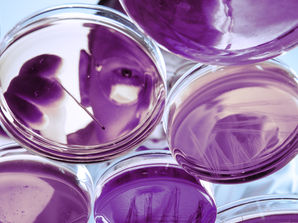
Scientist looking down a petri dishes.

top of page
Complete Writing Collection


Who Needs Vaccinations?
Diseases like measles, polio, smallpox, and tuberculosis still exist, and we need to vaccinate our children (and even ourselves again if necessary) to avoid multiple deadly outbreaks.
2 min read

Science Under Attack
Americans need the understanding and technologies that comprehensive scientific research projects produce and that robust health agencies provide.
2 min read


Congress: "Read Your Homework!"
Congress must do its homework! Our elected representatives are tasked with voting in our best interests and not in the interests of a tantrum-throwing president whose only goal is to make his cronies, his family, and himself wealthier than we could ever dream of being.
2 min read
Post Archives
bottom of page



